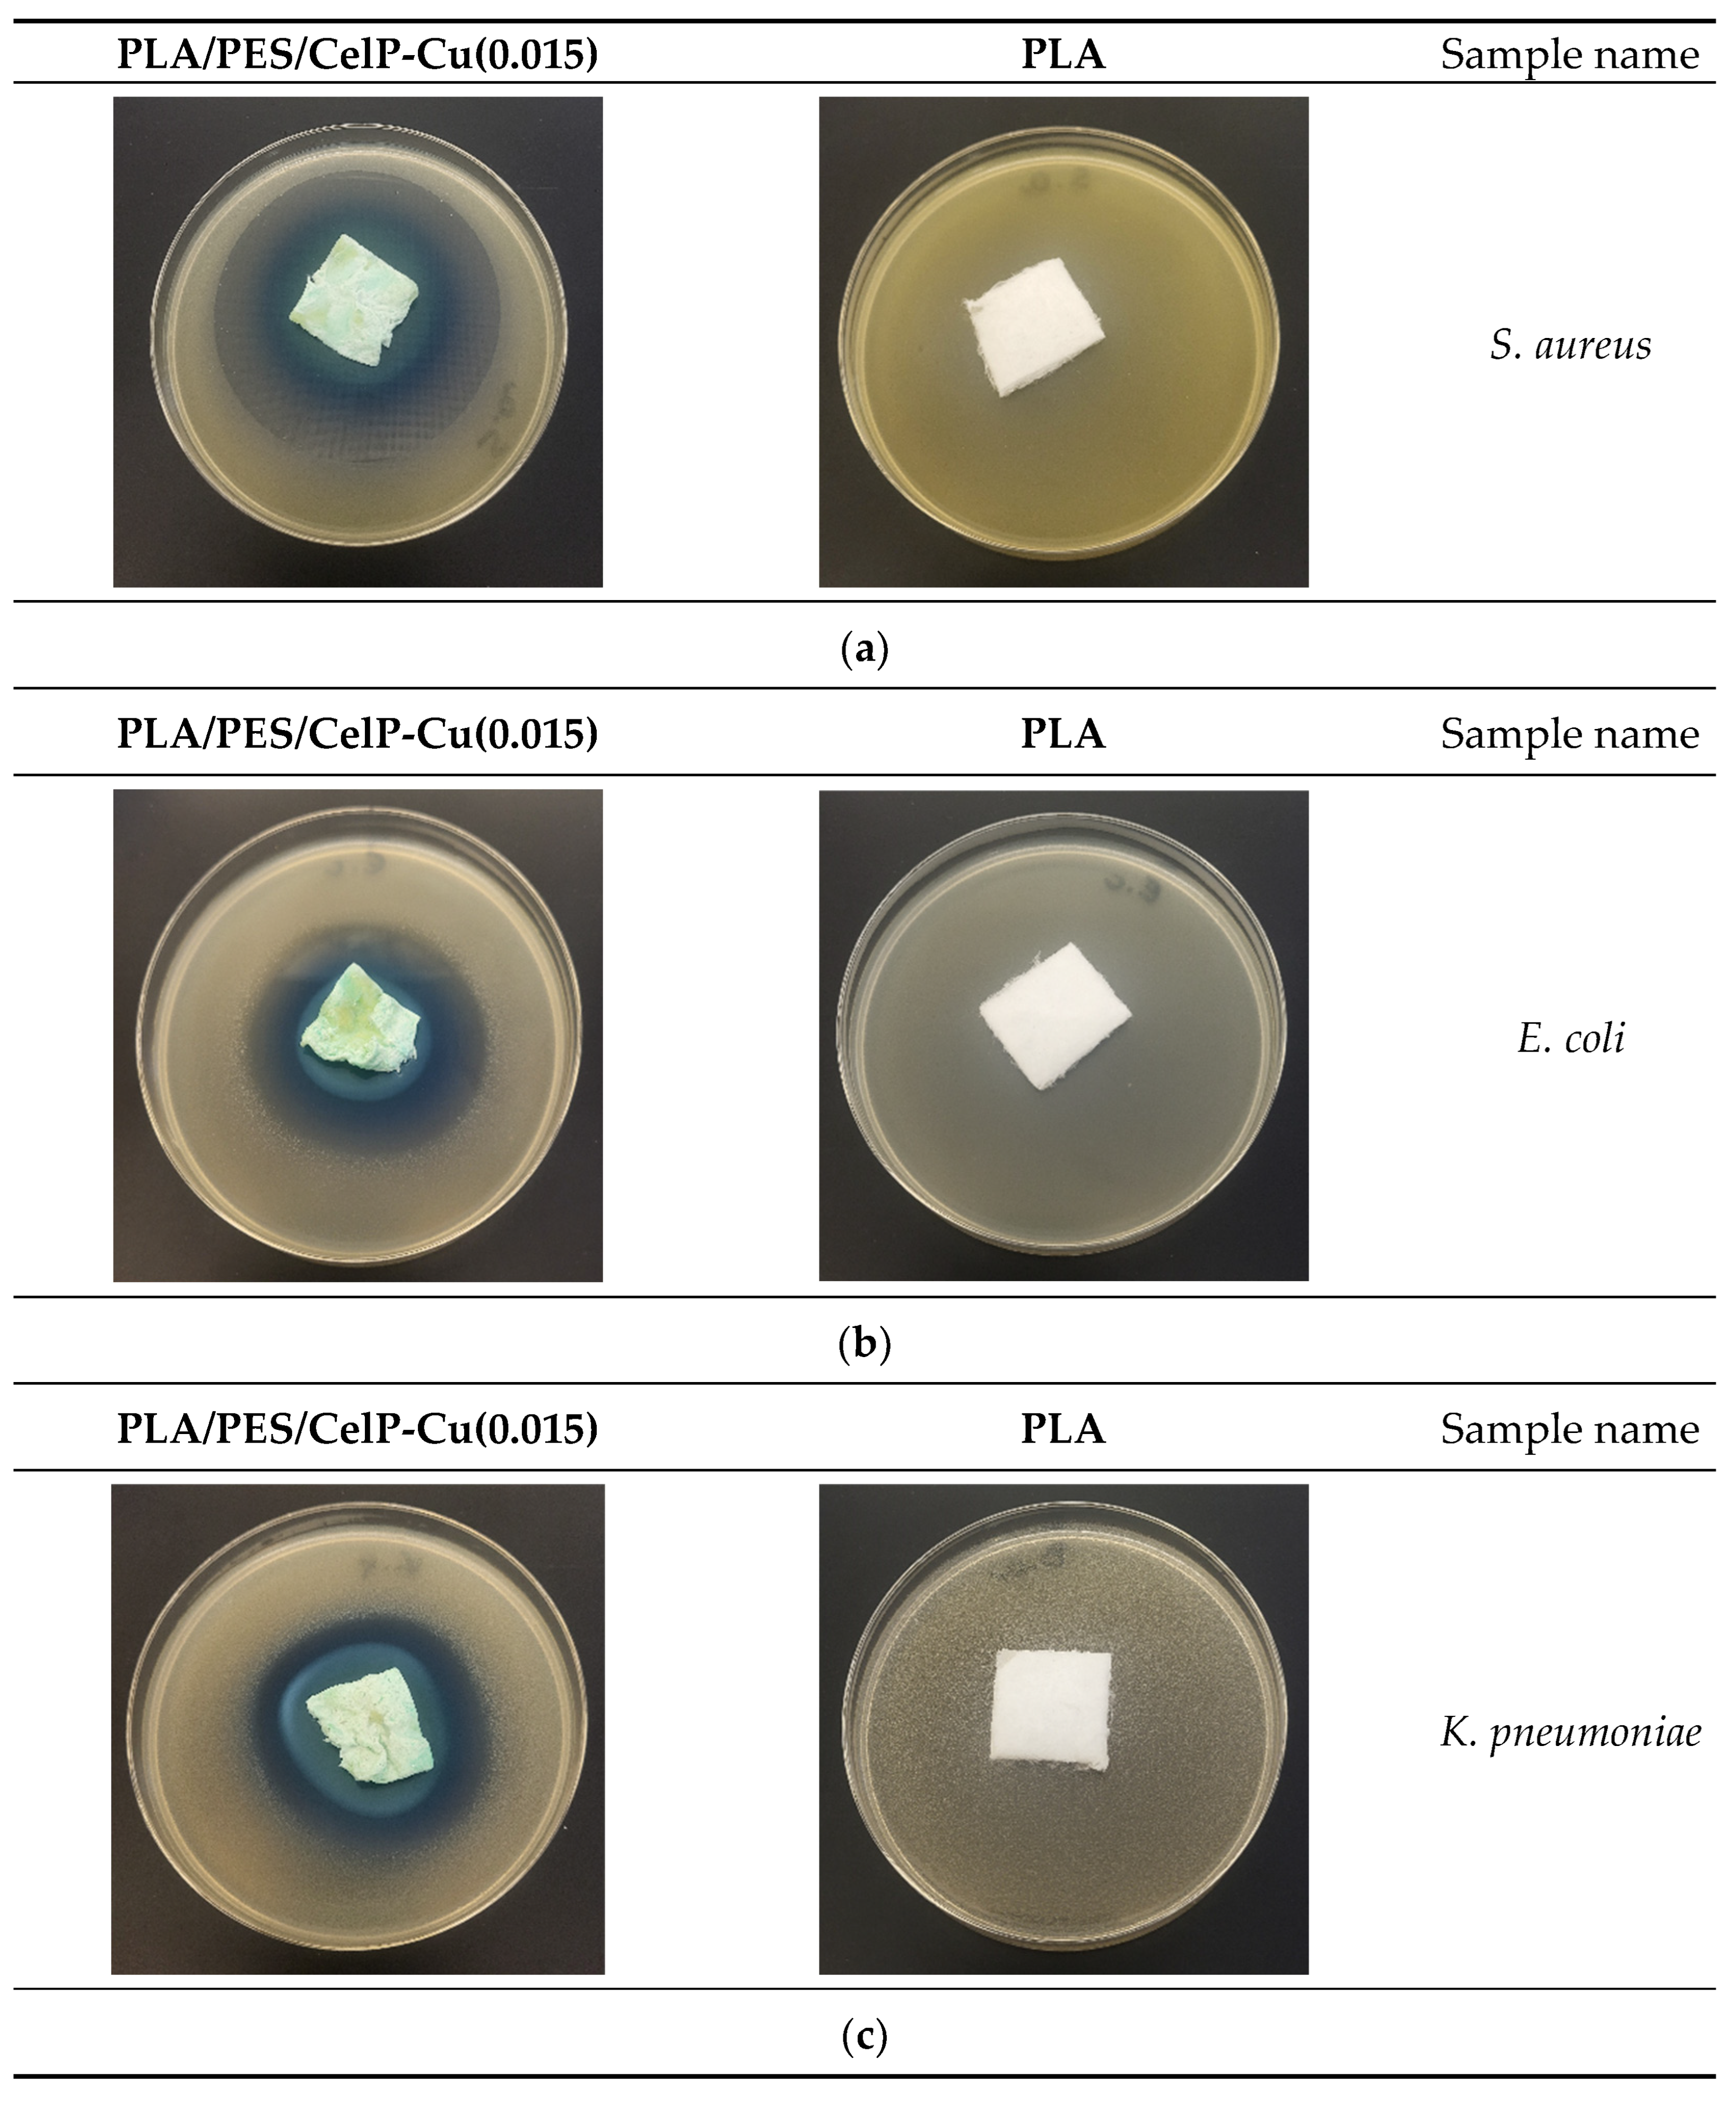
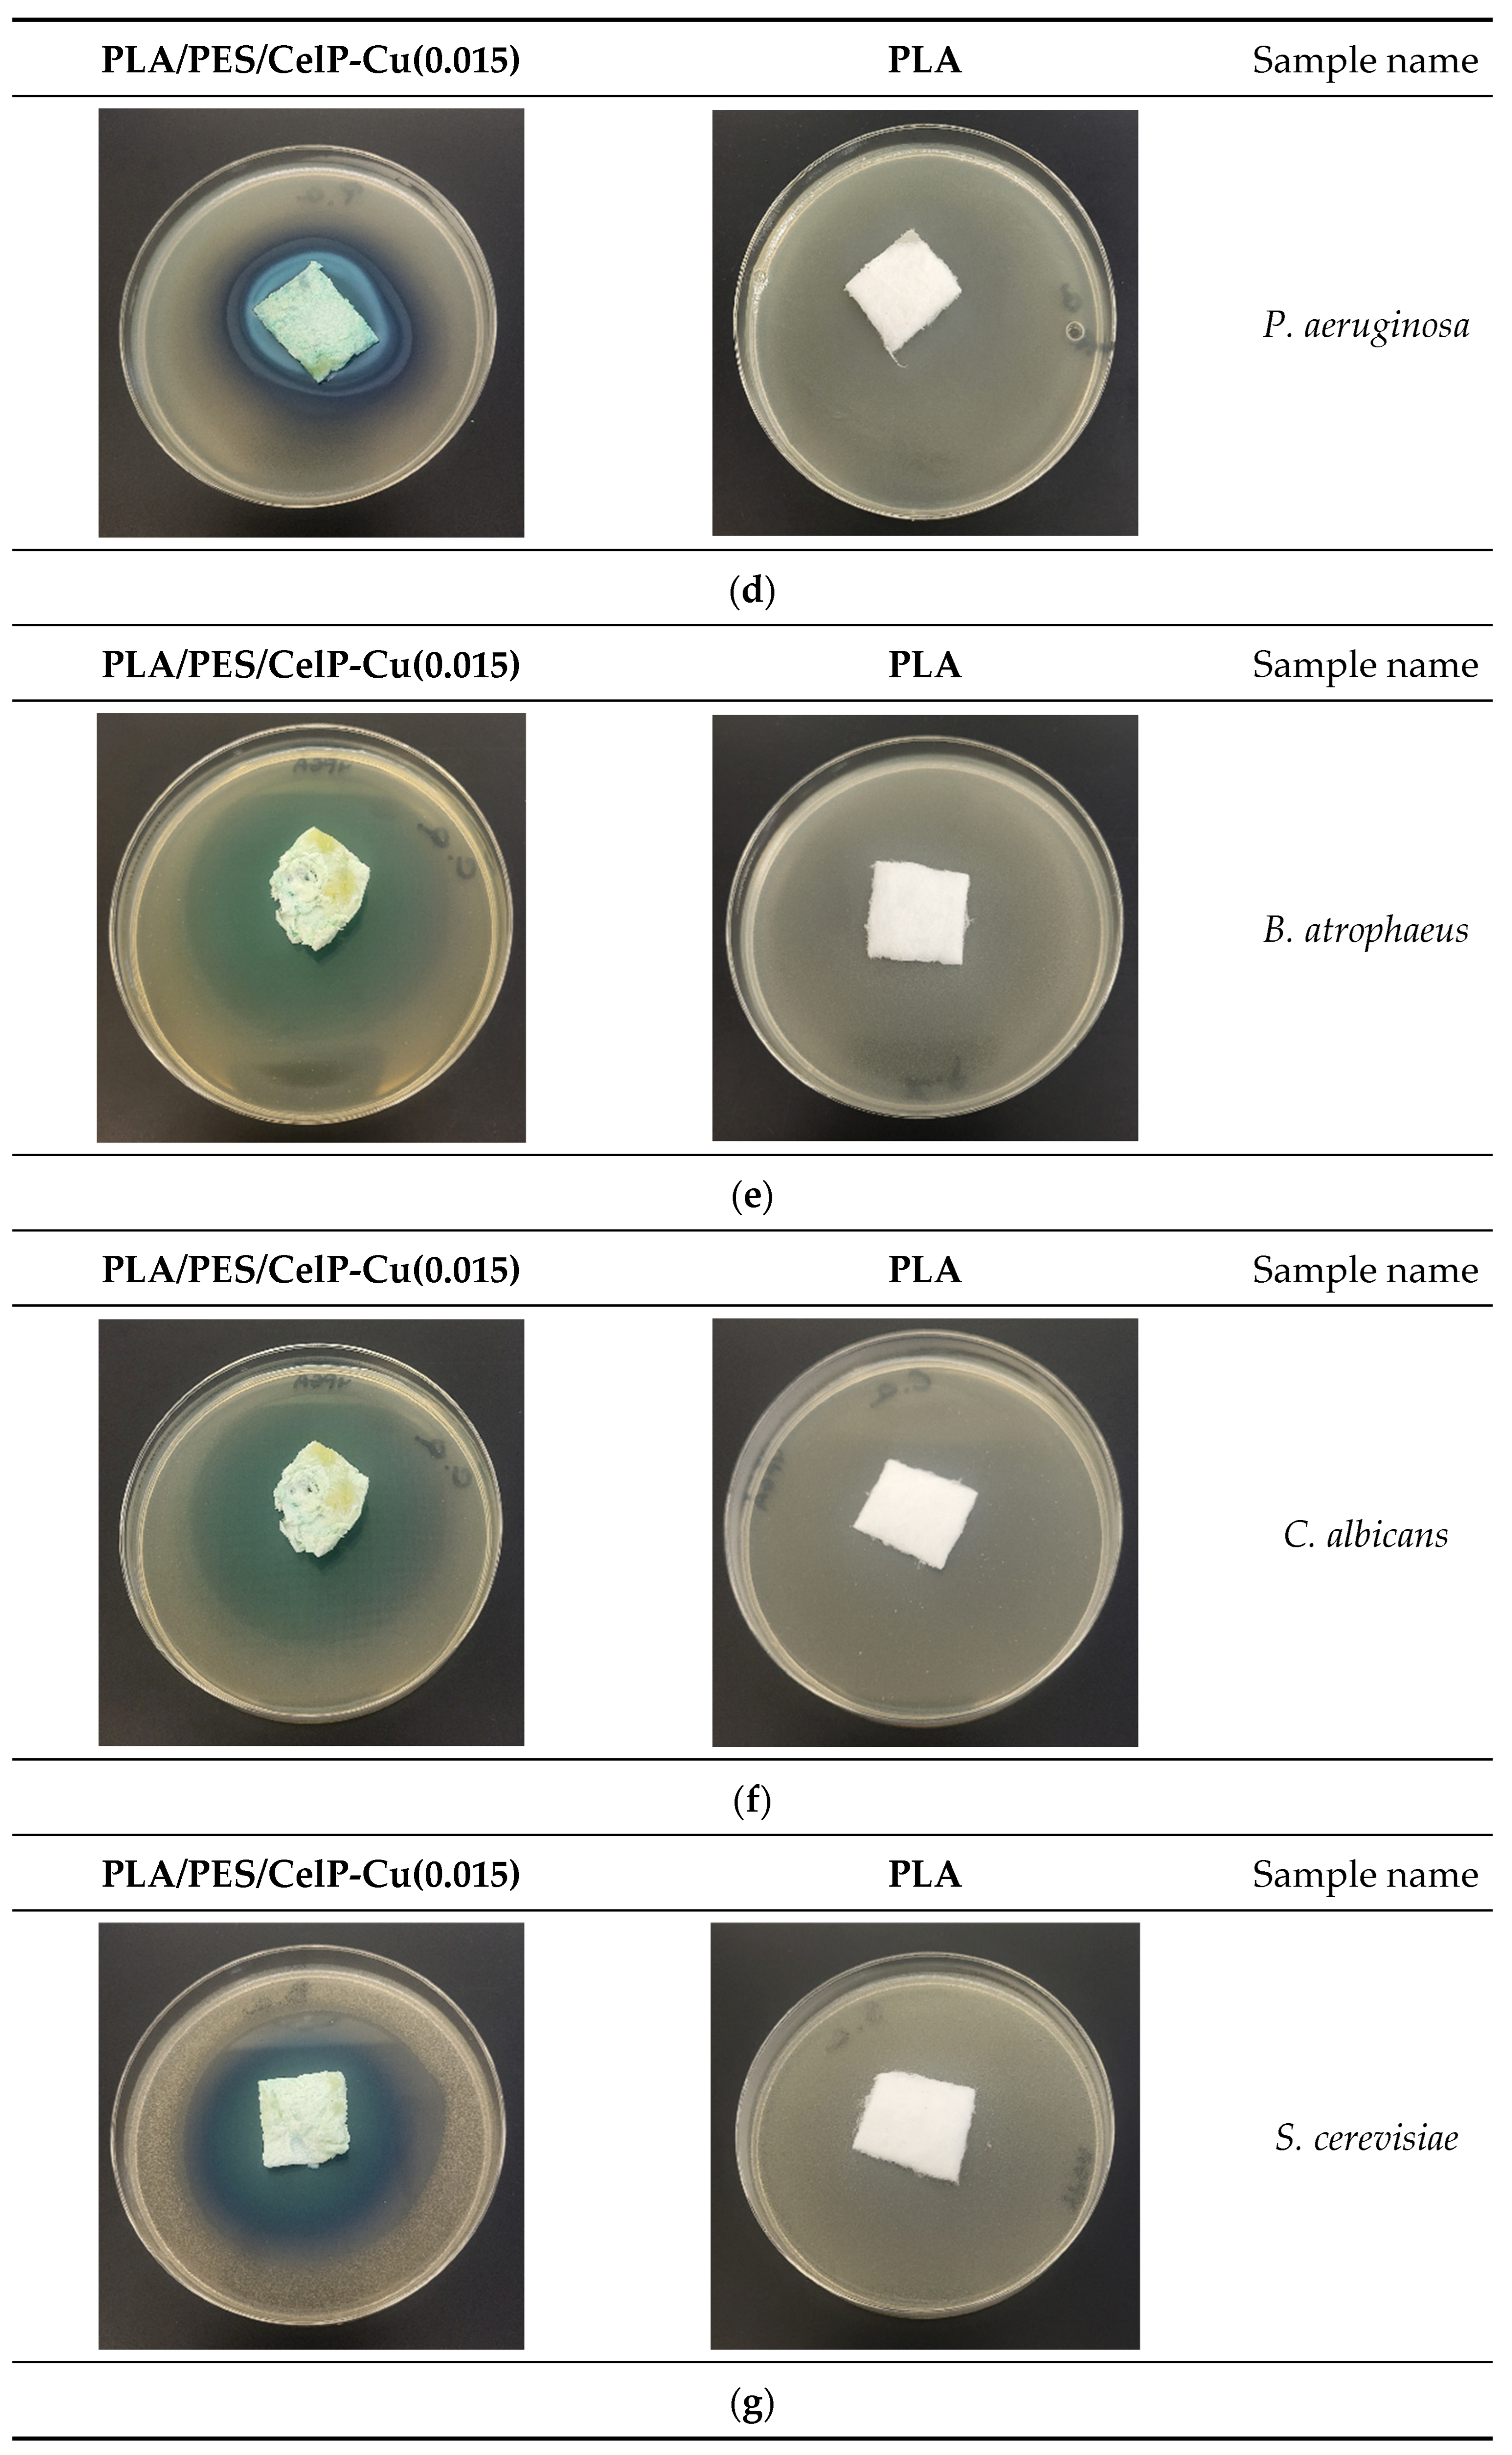

Preparation and Biochemical and Microbial Behavior of Poly(Lactide) Composites with Polyethersulfone and Copper-Complexed Cellulose Phosphate
Abstract
1. Introduction
2. Materials and Methods
2.1. Materials
- Poly(lactic acid) (PLA): The polymer was obtained from NatureWorks LLC (Minnetonka, MN, USA), type Ingeo™ Biopolymer 3251D, MFR = 30–40 g/10 min (190 °C/2.16 kg), Tm = 160–170 °C, glass transition temperature 55–60 °C, weight average molecular weight Mw = 55,400 g/mol, polydispersity index (PDI): Mw/Mn = 1.62, in the form of a granulate and was used for the fabrication of nonwoven samples.
- Reagents used for the preparation of composites: polyethersulfone (PESf) Ultrason E6020P from BASF (Ludwigshafen am Rhein, Germany)—weight average molecular mass Mw = 72,000 g/mol (by GPC in DMAc, PMMA standard), PDI (Mw/Mn = 3.5) (producer’s data); polyvinylpyrrolidone (PVP) from Sigma-Aldrich (St. Louis, MO, USA)—average Mw ~29,000 g/mol (producer’s data); 1-methyl-2-pyrrolidone (NMP) from Chemland (Stargard, Poland); cellulose phosphate from Sigma-Aldrich (St. Louis, MO, USA); and copper(II)chloride from Sigma-Aldrich (St. Louis, MO, USA).
- Microorganisms used in the analyses: Staphylococcus aureus (ATCC 6538), Escherichia coli (ATCC 11229), Klebsiella pneumoniae (ATCC 4352), Pseudomonas aeruginosa (ATCC 27853), Bacillus atrophaeus (ATCC 9372), Candida albicans (ATCC 10231), Saccharomyces cerevisiae (ATCC 9763), Aspergillus niger (ATCC 6275), Chaetomium globosum (ATCC 6205) were purchased from Microbiologics (St. Cloud, MN, USA).
- Standard human blood plasma lyophilizates (Dia-CONT I), aPTT reagent (Dia-PTT), PT reagent (Dia-PT), and 0.025 M CaCl2 solution reagent were obtained from Diagon Kft (Budapest, Hungary), as well as a coagulometer (K-3002 OPTIC, KSELMED®, Grudziądz, Poland), were utilized for the experiments. All the reagents were prepared in accordance with the manufacturer’s instructions.
2.2. Methods
2.2.1. Preparation of PLA/PESf/CelP-Cu Composites
Poly(Lactic Acid) Nonwoven Fabrics
Poly(Lactic Acid) Nonwoven Fabric Coating Procedure
Polymer Solution
Composite Preparation
2.2.2. Copper Content in Composite Materials by Flame Atomic Absorption Spectrometry (FAAS)
- C—metal concentration in the mineralized PLA/PESf/CelP-Cu sample solution [mg/L];
- m—mass of the mineralized sample of PLA/PESf/CelP-Cu composites [g];
- V—volume of the sample solution [mL].
2.2.3. Analysis of Surface Morphology
2.2.4. Evaluation of Antimicrobial Activity
2.2.5. Evaluation of Activated Partial Thromboplastin Time (aPTT) and Prothrombin Time (PT) Measurements
3. Results and Discussion
3.1. Physical Properties of PLA/PES/CelP-Cu Composites
3.1.1. FAAS Analysis for Copper Content and Surface Properties
3.1.2. Surface Characteristics
3.2. Biological Characteristics
3.2.1. Antimicrobial Effect
3.2.2. Impact on Plasma Coagulation: Assessment Through aPTT and PT Measurement
4. Conclusions
Author Contributions
Funding
Institutional Review Board Statement
Informed Consent Statement
Data Availability Statement
Acknowledgments
Conflicts of Interest
References
- Wasyłeczko, M.; Wojciechowski, C.; Chwojnowski, A. Polyethersulfone Polymer for Biomedical Applications and Biotechnology. Int. J. Mol. Sci. 2024, 25, 4233. [Google Scholar] [CrossRef] [PubMed]
- Song, R.; Murphy, M.; Li, C.; Ting, K.; Soo, C.; Zheng, Z. Current Development of Biodegradable Polymeric Materials for Biomedical Applications. Drug Des. Dev. Ther. 2018, 12, 3117–3145. [Google Scholar] [CrossRef] [PubMed]
- Asghari, F.; Samiei, M.; Adibkia, K.; Akbarzadeh, A.; Davaran, S. Biodegradable and Biocompatible Polymers for Tissue Engineering Application: A Review. Artif. Cells Nanomed. Biotechnol. 2017, 45, 185–192. [Google Scholar] [CrossRef] [PubMed]
- Gobi, R.; Ravichandiran, P.; Babu, R.S.; Yoo, D.J. Biopolymer and Synthetic Polymer-Based Nanocomposites in Wound Dressing Applications: A Review. Polymers 2021, 13, 1962. [Google Scholar] [CrossRef]
- Hammonds, R.L.; Gazzola, W.H.; Benson, R.S. Physical and Thermal Characterization of Polylactic Acid Meltblown Nonwovens. J. Appl. Polym. Sci. 2014, 131, 40593. [Google Scholar] [CrossRef]
- Morent, R.; De Geyter, N.; Desmet, T.; Dubruel, P.; Leys, C. Plasma Surface Modification of Biodegradable Polymers: A Review. Plasma Process. Polym. 2011, 8, 171–190. [Google Scholar] [CrossRef]
- Badaraev, A.D.; Nemoykina, A.L.; Bolbasov, E.N.; Tverdokhlebov, S.I. PLLA Scaffold Modification Using Magnetron Sputtering of the Copper Target to Provide Antibacterial Properties. Resour.-Effic. Technol. 2017, 3, 204–211. [Google Scholar] [CrossRef]
- Farah, S.; Anderson, D.G.; Langer, R. Physical and Mechanical Properties of PLA, and Their Functions in Widespread Applications—A Comprehensive Review. Adv. Drug Deliv. Rev. 2016, 107, 367–392. [Google Scholar] [CrossRef]
- DeStefano, V.; Khan, S.; Tabada, A. Applications of PLA in Modern Medicine. Eng. Regen. 2020, 1, 76–87. [Google Scholar] [CrossRef]
- Zhou, J.; Han, S.; Dou, Y.; Lu, J.; Wang, C.; He, H.; Li, X.; Zhang, J. Nanostructured Poly(l-Lactide) Matrix as Novel Platform for Drug Delivery. Int. J. Pharm. 2013, 448, 175–188. [Google Scholar] [CrossRef]
- Pandey, A.K.; Dwivedi, A.K. Recent Advancement in Wound Healing Dressing Material. Int. J. Pharm. Sci. Res. 2019, 10, 2572–2577. [Google Scholar] [CrossRef]
- Sharif, A.; Mondal, S.; Hoque, M.E. Polylactic Acid (PLA)-Based Nanocomposites: Processing and Properties. In Bio-Based Polymers and Nanocomposites: Preparation, Processing, Properties & Performance; Sanyang, M.L., Jawaid, M., Eds.; Springer International Publishing: Cham, Switzerland, 2019; pp. 233–254. ISBN 978-3-030-05825-8. [Google Scholar]
- Alam, F.; Shukla, V.R.; Varadarajan, K.M.; Kumar, S. Microarchitected 3D Printed Polylactic Acid (PLA) Nanocomposite Scaffolds for Biomedical Applications. J. Mech. Behav. Biomed. Mater. 2020, 103, 103576. [Google Scholar] [CrossRef] [PubMed]
- Essa, D.; Kondiah, P.P.D.; Choonara, Y.E.; Pillay, V. The Design of Poly(Lactide-Co-Glycolide) Nanocarriers for Medical Applications. Front. Bioeng. Biotechnol. 2020, 8, 48. [Google Scholar] [CrossRef] [PubMed]
- Wu, D.; Spanou, A.; Diez-Escudero, A.; Persson, C. 3D-Printed PLA/HA Composite Structures as Synthetic Trabecular Bone: A Feasibility Study Using Fused Deposition Modeling. J. Mech. Behav. Biomed. Mater. 2020, 103, 103608. [Google Scholar] [CrossRef]
- Davachi, S.M.; Kaffashi, B. Polylactic Acid in Medicine. Polym.-Plast. Technol. Eng. 2015, 54, 944–967. [Google Scholar] [CrossRef]
- Hamad, K.; Kaseem, M.; Yang, H.W.; Deri, F.; Ko, Y.G. Properties and Medical Applications of Polylactic Acid: A Review. Express Polym. Lett. 2015, 9, 435–455. [Google Scholar] [CrossRef]
- Santoro, M.; Shah, S.R.; Walker, J.L.; Mikos, A.G. Poly(Lactic Acid) Nanofibrous Scaffolds for Tissue Engineering. Adv. Drug Deliv. Rev. 2016, 107, 206–212. [Google Scholar] [CrossRef]
- Bergström, J.S.; Hayman, D. An Overview of Mechanical Properties and Material Modeling of Polylactide (PLA) for Medical Applications. Ann. Biomed. Eng. 2016, 44, 330–340. [Google Scholar] [CrossRef]
- Ramot, Y.; Haim-Zada, M.; Domb, A.J.; Nyska, A. Biocompatibility and Safety of PLA and Its Copolymers. Adv. Drug Deliv. Rev. 2016, 107, 153–162. [Google Scholar] [CrossRef]
- Hassani, F.; Mousavi, S.M.; Saghatoleslami, N.; Ghaffarian, V. Polyethersulfone/Poly(D,L-Lactide) Blend Membranes: Preparation, Characterization, and Performance. Chem. Eng. Technol. 2014, 37, 1065–1071. [Google Scholar] [CrossRef]
- Rasal, R.M.; Janorkar, A.V.; Hirt, D.E. Poly(Lactic Acid) Modifications. Prog. Polym. Sci. 2010, 35, 338–356. [Google Scholar] [CrossRef]
- Irfan, M.; Idris, A. Overview of PES Biocompatible/Hemodialysis Membranes: PES–Blood Interactions and Modification Techniques. Mater. Sci. Eng. C 2015, 56, 574–592. [Google Scholar] [CrossRef]
- Nie, S.; Xue, J.; Lu, Y.; Liu, Y.; Wang, D.; Sun, S.; Ran, F.; Zhao, C. Improved Blood Compatibility of Polyethersulfone Membrane with a Hydrophilic and Anionic Surface. Colloids Surf. B Biointerfaces 2012, 100, 116–125. [Google Scholar] [CrossRef]
- Song, X.; Ji, H.; Zhao, W.; Sun, S.; Zhao, C. Hemocompatibility Enhancement of Polyethersulfone Membranes: Strategies and Challenges. Adv. Membr. 2021, 1, 100013. [Google Scholar] [CrossRef]
- Tang, M.; Xue, J.; Yan, K.; Xiang, T.; Sun, S.; Zhao, C. Heparin-like Surface Modification of Polyethersulfone Membrane and Its Biocompatibility. J. Colloid Interface Sci. 2012, 386, 428–440. [Google Scholar] [CrossRef] [PubMed]
- Yang, Y.; Lu, Y.-T.; Zeng, K.; Heinze, T.; Groth, T.; Zhang, K. Recent Progress on Cellulose-Based Ionic Compounds for Biomaterials. Adv. Mater. 2021, 33, 2000717. [Google Scholar] [CrossRef]
- Granja, P.L.; Jéso, B.D.; Bareille, R.; Rouais, F.; Baquey, C.; Barbosa, M.A. Cellulose Phosphates as Biomaterials. In Vitro Biocompatibility Studies. React. Funct. Polym. 2006, 66, 728–739. [Google Scholar] [CrossRef]
- Granja, P.L.; Pouységu, L.; Pétraud, M.; De Jéso, B.; Baquey, C.; Barbosa, M.A. Cellulose Phosphates as Biomaterials. I. Synthesis and Characterization of Highly Phosphorylated Cellulose Gels. J. Appl. Polym. Sci. 2001, 82, 3341–3353. [Google Scholar] [CrossRef]
- Granja, P.L.; Pouységu, L.; Deffieux, D.; Daudé, G.; De Jéso, B.; Labrugère, C.; Baquey, C.; Barbosa, M.A. Cellulose Phosphates as Biomaterials. II. Surface Chemical Modification of Regenerated Cellulose Hydrogels. J. Appl. Polym. Sci. 2001, 82, 3354–3365. [Google Scholar] [CrossRef]
- Sinha, T.J.M.; Vasudevan, P. Blood-Cellulosics Interactions. Biomater. Med. Devices Artif. Organs 1984, 12, 273–287. [Google Scholar] [CrossRef]
- Groth, T.; Wagenknecht, W. Anticoagulant Potential of Regioselective Derivatized Cellulose. Biomaterials 2001, 22, 2719–2729. [Google Scholar] [CrossRef] [PubMed]
- Granja, P.L.; Barbosa, M.A.; Pouységu, L.; De Jéso, B.; Rouais, F.; Baquey, C. Cellulose Phosphates as Biomaterials. Mineralization of Chemically Modified Regenerated Cellulose Hydrogels. J. Mater. Sci. 2001, 36, 2163–2172. [Google Scholar] [CrossRef]
- Schimper, C.B.; Pachschwöll, P.; Maitz, M.F.; Werner, C.; Rosenau, T.; Liebner, F. Hemocompatibility of Cellulose Phosphate Aerogel Membranes with Potential Use in Bone Tissue Engineering. Front. Bioeng. Biotechnol. 2023, 11, 1152577. [Google Scholar] [CrossRef] [PubMed]
- Kudzin, M.H.; Mrozińska, Z.; Urbaniak, P. Vapor Phosphorylation of Cellulose by Phosphorus Trichlo-Ride: Selective Phosphorylation of 6-Hydroxyl Function—The Synthesis of New Antimicrobial Cellulose 6-Phosphate(III)-Copper Complexes. Antibiotics 2021, 10, 203. [Google Scholar] [CrossRef]
- Uriu-Adams, J.Y.; Keen, C.L. Copper, Oxidative Stress, and Human Health. Mol. Aspects Med. 2005, 26, 268–298. [Google Scholar] [CrossRef]
- Gaetke, L.M.; Chow, C.K. Copper Toxicity, Oxidative Stress, and Antioxidant Nutrients. Toxicology 2003, 189, 147–163. [Google Scholar] [CrossRef]
- Emam, H.E.; Manian, A.P.; Široká, B.; Duelli, H.; Merschak, P.; Redl, B.; Bechtold, T. Copper(I)Oxide Surface Modified Cellulose Fibers—Synthesis, Characterization and Antimicrobial Properties. Surf. Coat. Technol. 2014, 254, 344–351. [Google Scholar] [CrossRef]
- Cady, N.C.; Behnke, J.L.; Strickland, A.D. Copper-Based Nanostructured Coatings on Natural Cellulose: Nanocomposites Exhibiting Rapid and Efficient Inhibition of a Multi-Drug Resistant Wound Pathogen, A. Baumannii, and Mammalian Cell Biocompatibility In Vitro. Adv. Funct. Mater. 2011, 21, 2506–2514. [Google Scholar] [CrossRef]
- Vincent, M.; Hartemann, P.; Engels-Deutsch, M. Antimicrobial Applications of Copper. Int. J. Hyg. Environ. Health 2016, 219, 585–591. [Google Scholar] [CrossRef]
- Ingle, A.P.; Duran, N.; Rai, M. Bioactivity, Mechanism of Action, and Cytotoxicity of Copper-Based Nanoparticles: A Review. Appl. Microbiol. Biotechnol. 2014, 98, 1001–1009. [Google Scholar] [CrossRef]
- Borkow, G.; Gabbay, J. Putting Copper into Action: Copper-Impregnated Products with Potent Biocidal Activities. FASEB J. 2004, 18, 1728–1730. [Google Scholar] [CrossRef]
- Heliopoulos, N.S.; Papageorgiou, S.K.; Galeou, A.; Favvas, E.P.; Katsaros, F.K.; Stamatakis, K. Effect of Copper and Copper Alginate Treatment on Wool Fabric. Study of Textile and Antibacterial Properties. Surf. Coat. Technol. 2013, 235, 24–31. [Google Scholar] [CrossRef]
- Kudzin, M.H.; Kaczmarek, A.; Mrozińska, Z.; Olczyk, J. Deposition of Copper on Polyester Knitwear Fibers by a Magnetron Sputtering System. Physical Properties and Evaluation of Antimicrobial Response of New Multi-Functional Composite Materials. Appl. Sci. 2020, 10, 6990. [Google Scholar] [CrossRef]
- Kudzin, M.H.; Boguń, M.; Mrozińska, Z.; Kaczmarek, A. Physical Properties, Chemical Analysis, and Evaluation of Antimicrobial Response of New Polylactide/Alginate/Copper Composite Materials. Mar. Drugs 2020, 18, 660. [Google Scholar] [CrossRef] [PubMed]
- Kudzin, M.H.; Mrozińska, Z.; Kaczmarek, A.; Lisiak-Kucińska, A. Deposition of Copper on Poly(Lactide) Non-Woven Fabrics by Magnetron Sputtering—Fabrication of New Multi-Functional, Antimicrobial Composite Materials. Materials 2020, 13, 3971. [Google Scholar] [CrossRef]
- Slavin, Y.N.; Asnis, J.; Häfeli, U.O.; Bach, H. Metal Nanoparticles: Understanding the Mechanisms behind Antibacterial Activity. J. Nanobiotechnol. 2017, 15, 65. [Google Scholar] [CrossRef]
- Sánchez-López, E.; Gomes, D.; Esteruelas, G.; Bonilla, L.; Lopez-Machado, A.L.; Galindo, R.; Cano, A.; Espina, M.; Ettcheto, M.; Camins, A.; et al. Metal-Based Nanoparticles as Antimicrobial Agents: An Overview. Nanomaterials 2020, 10, 292. [Google Scholar] [CrossRef]
- Giannousi, K.; Pantazaki, A.; Dendrinou-Samara, C. Chapter 23—Copper-Based Nanoparticles as Antimicrobials. In Nanostructures for Antimicrobial Therapy; Micro and Nano Technologies; Ficai, A., Grumezescu, A.M., Eds.; Elsevier: Amsterdam, The Netherlands, 2017; pp. 515–529. ISBN 978-0-323-46152-8. [Google Scholar]
- Dalecki, A.G.; Crawford, C.L.; Wolschendorf, F. Chapter Six—Copper and Antibiotics: Discovery, Modes of Action, and Opportunities for Medicinal Applications. In Advances in Microbial Physiology; Microbiology of Metal Ions; Poole, R.K., Ed.; Academic Press: Cambridge, MA, USA, 2017; Volume 70, pp. 193–260. [Google Scholar]
- Chatterjee, A.K.; Chakraborty, R.; Basu, T. Mechanism of Antibacterial Activity of Copper Nanoparticles. Nanotechnology 2014, 25, 135101. [Google Scholar] [CrossRef]
- Vincent, M.; Duval, R.E.; Hartemann, P.; Engels-Deutsch, M. Contact Killing and Antimicrobial Properties of Copper. J. Appl. Microbiol. 2018, 124, 1032–1046. [Google Scholar] [CrossRef]
- Bastos, C.A.P.; Faria, N.; Wills, J.; Malmberg, P.; Scheers, N.; Rees, P.; Powell, J.J. Copper Nanoparticles Have Negligible Direct Antibacterial Impact. NanoImpact 2020, 17, 100192. [Google Scholar] [CrossRef]
- Ramos-Zúñiga, J.; Bruna, N.; Pérez-Donoso, J.M. Toxicity Mechanisms of Copper Nanoparticles and Copper Surfaces on Bacterial Cells and Viruses. Int. J. Mol. Sci. 2023, 24, 10503. [Google Scholar] [CrossRef]
- Chang, T.; Babu, R.P.; Zhao, W.; Johnson, C.M.; Hedström, P.; Odnevall, I.; Leygraf, C. High-Resolution Microscopical Studies of Contact Killing Mechanisms on Copper-Based Surfaces. ACS Appl. Mater. Interfaces 2021, 13, 49402–49413. [Google Scholar] [CrossRef] [PubMed]
- Grass, G.; Rensing, C.; Solioz, M. Metallic Copper as an Antimicrobial Surface. Appl. Environ. Microbiol. 2011, 77, 1541–1547. [Google Scholar] [CrossRef] [PubMed]
- Perelshtein, I.; Applerot, G.; Perkas, N.; Wehrschuetz-Sigl, E.; Hasmann, A.; Guebitz, G.; Gedanken, A. CuO–Cotton Nanocomposite: Formation, Morphology, and Antibacterial Activity. Surf. Coat. Technol. 2009, 204, 54–57. [Google Scholar] [CrossRef]
- Emam, H.E.; Ahmed, H.B.; Bechtold, T. In-Situ Deposition of Cu 2 O Micro-Needles for Biologically Active Textiles and Their Release Properties. Carbohydr. Polym. 2017, 165, 255–265. [Google Scholar] [CrossRef] [PubMed]
- Bajpai, S.K.; Bajpai, M.; Sharma, L. Copper Nanoparticles Loaded Alginate-Impregnated Cotton Fabric with Antibacterial Properties. J. Appl. Polym. Sci. 2012, 126, E319–E326. [Google Scholar] [CrossRef]
- Alizadeh, S.; Seyedalipour, B.; Shafieyan, S.; Kheime, A.; Mohammadi, P.; Aghdami, N. Copper Nanoparticles Promote Rapid Wound Healing in Acute Full Thickness Defect via Acceleration of Skin Cell Migration, Proliferation, and Neovascularization. Biochem. Biophys. Res. Commun. 2019, 517, 684–690. [Google Scholar] [CrossRef]
- Kornblatt, A.P.; Nicoletti, V.G.; Travaglia, A. The Neglected Role of Copper Ions in Wound Healing. J. Inorg. Biochem. 2016, 161, 1–8. [Google Scholar] [CrossRef]
- Borkow, G.; Gabbay, J.; Dardik, R.; Eidelman, A.I.; Lavie, Y.; Grunfeld, Y.; Ikher, S.; Huszar, M.; Zatcoff, R.C.; Marikovsky, M. Molecular Mechanisms of Enhanced Wound Healing by Copper Oxide-Impregnated Dressings. Wound Repair Regen. 2010, 18, 266–275. [Google Scholar] [CrossRef]
- Sen, C.K.; Khanna, S.; Venojarvi, M.; Trikha, P.; Ellison, E.C.; Hunt, T.K.; Roy, S. Copper-Induced Vascular Endothelial Growth Factor Expression and Wound Healing. Am. J. Physiol.-Heart Circ. Physiol. 2002, 282, H1821–H1827. [Google Scholar] [CrossRef]
- Cucci, L.M.; Satriano, C.; Marzo, T.; La Mendola, D. Angiogenin and Copper Crossing in Wound Healing. Int. J. Mol. Sci. 2021, 22, 10704. [Google Scholar] [CrossRef] [PubMed]
- Tiwari, M.; Narayanan, K.; Thakar, M.B.; Jagani, H.V.; Venkata Rao, J. Biosynthesis and Wound Healing Activity of Copper Nanoparticles. IET Nanobiotechnol. 2014, 8, 230–237. [Google Scholar] [CrossRef]
- Cangul, I.T.; Gul, N.Y.; Topal, A.; Yilmaz, R. Evaluation of the Effects of Topical Tripeptide-Copper Complex and Zinc Oxide on Open-Wound Healing in Rabbits. Vet. Dermatol. 2006, 17, 417–423. [Google Scholar] [CrossRef] [PubMed]
- Mutch, N.J.; Waters, E.K.; Morrissey, J.H. Immobilized Transition Metals Stimulate Contact Activation and Drive Factor XII-Mediated Coagulation. J. Thromb. Haemost. 2012, 10, 2108–2115. [Google Scholar] [CrossRef] [PubMed]
- Elmer: Analytical Methods for Atomic Absorption Spectroscopy—Google Scholar. Available online: https://scholar.google.com/scholar_lookup?title=Analytical+Methods+for+Atomic+Absorption+Spectroscopy&author=The+Perkin%E2%80%93Elmer+Corporation&publication_year=1996 (accessed on 10 March 2025).
- EN ISO 20645:2006; Textile Fabrics—Determination of Antibacterial Activity—Agar Diffusion Plate Test. International Organization for Standardization: Geneva, Switzerland, 2006.
- PN-EN 14119:2005 Point 10.5 (B2); Testing of Textiles—Evaluation of the Action of Microfungi—Visual Method. British Standards Institution: London, UK, 2005.
- Kiel, A.; Kaltschmidt, B.P.; Asghari, E.; Hütten, A.; Kaltschmidt, B.; Kaltschmidt, C. Bacterial Biofilm Formation on Nano-Copper Added PLA Suited for 3D Printed Face Masks. Microorganisms 2022, 10, 439. [Google Scholar] [CrossRef]
- Ahmed, W.; Al-Marzouqi, A.H.; Nazir, M.H.; Rizvi, T.A.; Zaneldin, E.; Khan, M.; Aziz, M. Investigating the Properties and Characterization of a Hybrid 3D Printed Antimicrobial Composite Material Using FFF Process: Innovative and Swift. Int. J. Mol. Sci. 2023, 24, 8895. [Google Scholar] [CrossRef]
- Liu, C.; Shen, J.; Yeung, K.W.K.; Tjong, S.C. Development and Antibacterial Performance of Novel Polylactic Acid-Graphene Oxide-Silver Nanoparticle Hybrid Nanocomposite Mats Prepared By Electrospinning. ACS Biomater. Sci. Eng. 2017, 3, 471–486. [Google Scholar] [CrossRef]
- Mody, V.V.; Siwale, R.; Singh, A.; Mody, H.R. Introduction to Metallic Nanoparticles. J. Pharm. Bioallied Sci. 2010, 2, 282–289. [Google Scholar] [CrossRef]
- Uzair, B.; Liaqat, A.; Iqbal, H.; Menaa, B.; Razzaq, A.; Thiripuranathar, G.; Fatima Rana, N.; Menaa, F. Green and Cost-Effective Synthesis of Metallic Nanoparticles by Algae: Safe Methods for Translational Medicine. Bioengineering 2020, 7, 129. [Google Scholar] [CrossRef]
- Chu, Z.; Zhao, T.; Li, L.; Fan, J.; Qin, Y. Characterization of Antimicrobial Poly (Lactic Acid)/Nano-Composite Films with Silver and Zinc Oxide Nanoparticles. Materials 2017, 10, 659. [Google Scholar] [CrossRef]
- Hoang, M.H.; Thi Thanh, H.T.; Nguyen, D.N.; Van Nguyen, T.; Chyshankou, I.; Liubimau, A.; Dobysh, U.; Kulikouskaya, V. Antimicrobial Ultrathin Film Based on Well-Defined Silver Nanoparticles and Polylactide. Adv. Nat. Sci. Nanosci. Nanotechnol. 2020, 11, 025014. [Google Scholar] [CrossRef]
- Macha, I.J.; Muna, M.M.; Magere, J.L. In Vitro Study and Characterization of Cotton Fabric PLA Composite as a Slow Antibiotic Delivery Device for Biomedical Applications. J. Drug Deliv. Sci. Technol. 2018, 43, 172–177. [Google Scholar] [CrossRef]
- Alquwaizani, M.; Buckley, L.; Adams, C.; Fanikos, J. Anticoagulants: A Review of the Pharmacology, Dosing, and Complications. Curr. Emerg. Hosp. Med. Rep. 2013, 1, 83–97. [Google Scholar] [CrossRef] [PubMed]
- Rountree, K.M.; Yaker, Z.; Lopez, P.P. Partial Thromboplastin Time. In StatPearls; StatPearls Publishing: Treasure Island, FL, USA, 2025. [Google Scholar]
- Li, J.; Lai, X.; Yan, C.; Xu, A.; Nie, L.; Zhou, Y.; Liao, C.; Ren, H. Age-Associated Developmental Changes in the Activated Partial Thromboplastin Time (APTT) and Causes of Prolonged APTT Values in Healthy Chinese Children. Clin. Chem. Lab. Med. 2009, 47, 1531–1537. [Google Scholar] [CrossRef]
- Janvikul, W.; Uppanan, P.; Thavornyutikarn, B.; Krewraing, J.; Prateepasen, R. In Vitro Comparative Hemostatic Studies of Chitin, Chitosan, and Their Derivatives. J. Appl. Polym. Sci. 2006, 102, 445–451. [Google Scholar] [CrossRef]
- Jiao, S.; Zhang, X.; Cai, H.; Wu, S.; Ou, X.; Han, G.; Zhao, J.; Li, Y.; Guo, W.; Liu, T.; et al. Recent Advances in Biomimetic Hemostatic Materials. Mater. Today Bio 2023, 19, 100592. [Google Scholar] [CrossRef] [PubMed]
- Mrozińska, Z.; Kudzin, M.H.; Ponczek, M.B.; Kaczmarek, A.; Król, P.; Lisiak-Kucińska, A.; Żyłła, R.; Walawska, A. Biochemical Approach to Poly(Lactide)–Copper Composite—Impact on Blood Coagulation Processes. Materials 2024, 17, 608. [Google Scholar] [CrossRef]
- Mrozińska, Z.; Ponczek, M.; Kaczmarek, A.; Boguń, M.; Sulak, E.; Kudzin, M.H. Blood Coagulation Activities of Cotton–Alginate–Copper Composites. Mar. Drugs 2023, 21, 625. [Google Scholar] [CrossRef]

| Processing Parameters | |
|---|---|
| Temperature in zone 1 of the extruder | 195 °C |
| Temperature in zone 2 of the extruder | 245 °C |
| Temperature in zone 3 of the extruder | 260 °C |
| Temperature of the head | 260 °C |
| Temperature of the air heater | 260 °C |
| Airflow rate | 7–8 m3/h |
| Mass per unit area of the nonwovens | 95 g/m2 |
| Polymer yields | 6 g/min |
| Sample Name | Mixture Components of Film-Forming Solution (%) | |||
|---|---|---|---|---|
| Polyethersulfone | Cellulose Phosphate | Copper(II) Chloride (1%) | Copper(II) Chloride (10%) | |
| PLA | − | − | − | − |
| PLA/PES/CelP | + | + | − | − |
| PLA/PES/CelP-Cu-1 | + | + | + | − |
| PLA/PES/CelP-Cu-2 | + | + | − | + |
| No. | Sample Analyzed | Copper Deposition | Sample Code | |
|---|---|---|---|---|
| [mg/kg] | [mMol/kg] a,b | |||
| 1 | PLA | 0 | 0 | PLA |
| 2 | PLA/PES/CelP | 0 | 0 | PLA/PES/CelP |
| 3 | PLA/PES/CelP-Cu-1 | 0.9155 | 0.0014 | PLA/PES/CelP-Cu(0.0014) c |
| 4 | PLA/PES/CelP-Cu-2 | 9.5585 | 0.015 | PLA/PES/CelP-Cu(0.015) c |
| Sample Name | Element Symbol | Element Name | Atomic Conc. [%] | Weight Conc. [%] |
|---|---|---|---|---|
| PLA | C | Carbon | 56.041 | 48.900 |
| O | Oxygen | 43.959 | 51.100 | |
| PLA/PES/CelP | C | Carbon | 53.307 | 44.645 |
| N | Nitrogen | 4.201 | 4.104 | |
| O | Oxygen | 39.027 | 43.544 | |
| P | Phosphorus | 0.556 | 1.201 | |
| S | Sulfur | 2.909 | 6.507 | |
| PLA/PES/CelP-Cu(0.0014) | C | Carbon | 57.160 | 47.047 |
| N | Nitrogen | 5.943 | 5.706 | |
| O | Oxygen | 32.225 | 35.335 | |
| P | Phosphorus | 0.424 | 0.901 | |
| S | Sulfur | 3.143 | 6.907 | |
| Cl | Chlorine | 0.371 | 0.901 | |
| Cu | Copper | 0.736 | 3.203 | |
| PLA/PES/CelP-Cu(0.015) | C | Carbon | 57.570 | 47.100 |
| N | Nitrogen | 6.496 | 6.200 | |
| O | Oxygen | 30.736 | 33.500 | |
| P | Phosphorus | 0.284 | 0.600 | |
| S | Sulfur | 3.525 | 7.700 | |
| Cl | Chlorine | 0.580 | 1.400 | |
| Cu | Copper | 0.809 | 3.500 |
| No. | Sample Name | Average Inhibition Zone [mm] | ||||||||
|---|---|---|---|---|---|---|---|---|---|---|
| Bacteria and Fungi a | ||||||||||
| Bacteria | Fungi | |||||||||
| G+ | G− | |||||||||
| Ba | Sa | Ec | Kp | Pa | Ca | Sc | An | Cg | ||
| 1 | PLA | 0 | 0 | 0 | 0 | 0 | 0 | 0 | 0 | 0 |
| 2 | PLA/PES/CelP | 0 | 0 | 0 | 0 | 0 | 0 | 0 | 0 | 0 |
| 3 | PLA/PES/CelP-Cu(0.0014) | 5 | 4 | 6 | 7 | 6 | 6 | 4 | 4 | 6 |
| 4 | PLA/PES/CelP-Cu(0.015) | 7 | 6 | 6 | 7 | 7 | 9 | 8 | 9 | 8 |
| aPTT | |||||
|---|---|---|---|---|---|
| Sample | PLA | PLA/PES/CelP | PLA/PES/CelP-Cu(0.0014) | PLA/PES/CelP-Cu(0.015) | C |
| Mean | 35.4 | 42.1 | 44.57 | 49.18 | 38.40 |
| SD | 0.63 | 0.73 | 0.52 | 1.37 | 0.71 |
| Median | 35.3 | 42.25 | 44.50 | 49.6 | 38.40 |
| PT | |||||
|---|---|---|---|---|---|
| Sample | PLA | PLA/PES/CelP | PLA/PES/CelP-Cu(0.0014) | PLA/PES/CelP-Cu(0.015) | Control Sample |
| Mean | 13.65 | 13.90 | 15.40 | 15.15 | 13.1 |
| SD | 0.80 | 1.3 | 1.60 | 1.1 | 0.57 |
| Median | 13.7 | 13.9 | 15.40 | 15.2 | 13.1 |
Disclaimer/Publisher’s Note: The statements, opinions and data contained in all publications are solely those of the individual author(s) and contributor(s) and not of MDPI and/or the editor(s). MDPI and/or the editor(s) disclaim responsibility for any injury to people or property resulting from any ideas, methods, instructions or products referred to in the content. |
© 2025 by the authors. Licensee MDPI, Basel, Switzerland. This article is an open access article distributed under the terms and conditions of the Creative Commons Attribution (CC BY) license (https://creativecommons.org/licenses/by/4.0/).
Share and Cite
Kudzin, M.H.; Mrozińska, Z.; Kaczmarek, A.; Chruściel, J.J.; Gloc, M.; Żyłła, R. Preparation and Biochemical and Microbial Behavior of Poly(Lactide) Composites with Polyethersulfone and Copper-Complexed Cellulose Phosphate. Materials 2025, 18, 2954. https://doi.org/10.3390/ma18132954
Kudzin MH, Mrozińska Z, Kaczmarek A, Chruściel JJ, Gloc M, Żyłła R. Preparation and Biochemical and Microbial Behavior of Poly(Lactide) Composites with Polyethersulfone and Copper-Complexed Cellulose Phosphate. Materials. 2025; 18(13):2954. https://doi.org/10.3390/ma18132954
Chicago/Turabian StyleKudzin, Marcin H., Zdzisława Mrozińska, Anna Kaczmarek, Jerzy J. Chruściel, Martyna Gloc, and Renata Żyłła. 2025. "Preparation and Biochemical and Microbial Behavior of Poly(Lactide) Composites with Polyethersulfone and Copper-Complexed Cellulose Phosphate" Materials 18, no. 13: 2954. https://doi.org/10.3390/ma18132954
APA StyleKudzin, M. H., Mrozińska, Z., Kaczmarek, A., Chruściel, J. J., Gloc, M., & Żyłła, R. (2025). Preparation and Biochemical and Microbial Behavior of Poly(Lactide) Composites with Polyethersulfone and Copper-Complexed Cellulose Phosphate. Materials, 18(13), 2954. https://doi.org/10.3390/ma18132954






